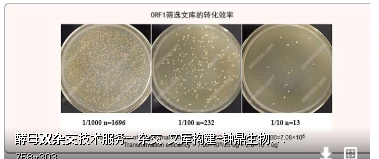

如何判断两个蛋白之间有相互作用
1、杂交指的是利用生物学探针,带有一些荧光标记的,如何其核酸序列能够跟所探测的序列互补上,那么就会有结合,通过探针可以定位我们所要寻找的序列的定位

2、酵母双杂交是一种用于检测两种蛋白是否互作的一种手段。比如想验证A,B两种蛋白是否有相互作用,实验中将A蛋白与转录激活因子连接,B蛋白与另一个转录因子(比如RNA聚合酶的alpha亚基)融合。
3、如果A能够和B发生互作,那么转录激活因子就可以激活报告基因的转录,从而使菌株产生某些特性(抗性或能够在基本培养基上生长),反之则不能
